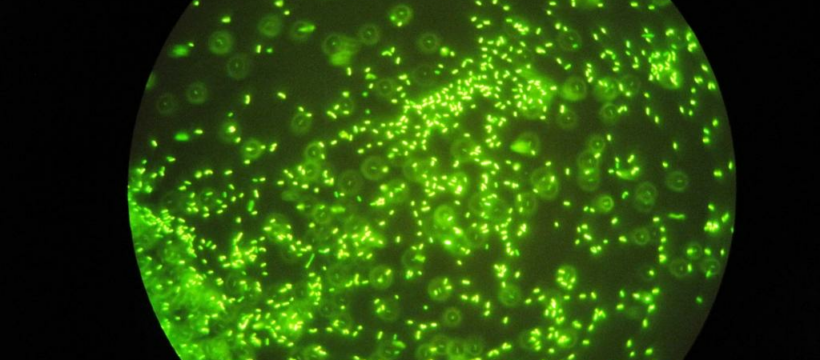

Mikrobiom-verbessernde Pflegeprodukte in europäische Leitlinie aufgenommen
Hennigsdorf b. Berlin, 31. Mai 2022 – Häufiges Desinfizieren oder Händewaschen kann Hautkrankheiten verursachen, wenn es das natürliche gesunde Mikrobiom der Haut schädigt und den gesunden Säureschutzmantel der Haut verletzt. Das kann zu Juckreiz, Rötungen, aber auch zu Neurodermitis, Rosazea oder Schuppenflechte (Psoriasis) führen oder diese Symptome und Krankheiten verstärken. Darauf hat Prof. Dr. Christine Lang, Mikrobiologin an der TU Berlin und wissenschaftlicher Vorstand der BELANO medical AG, in einem Gespräch mit dem Magazin NATUR & HEILEN hingewiesen.
In dem aktuell erschienenen Beitrag ( https://www.naturundheilen.de/artikel/das-mikrobiom-der-haut-unsere-unterschaetzte-schutzbarriere/) schildert Prof. Lang, wie gesunde Bakterien der Art Staphylococcus epidermidis gegen Entzündungskeime wie eine Art natürliches Antibiotikum wirken. Diese natürliche Balance im Mikrobiom der Haut scheine ein „Training für gute Bakterien“ zu sein. „Das führt dazu, dass unser Immunsystem in der Haut ebenfalls Abwehrstoffe produziert“, zitiert der Beitrag Christine Lang. Die schädlichen Bakterien einfach nur weg zu desinfizieren, sei daher kontraproduktiv. Eine intakte Hautoberfläche brauche das Zusammenspiel verschiedener Bakterien. Ziel müsse es daher sein, ein Übermaß an schädigenden Mikroorganismen zu reduzieren und gleichzeitig das Wachstum gesunder Bakterien auf der Haut zu fördern.
Klinische Studien für wirksame Produkte aus Bakterien
Geeignete Mikrobiom-fördernde Arzneimittel gegen Neurodermitis oder andere Erkrankungen gebe es trotz dieser wissenschaftlichen Erkenntnis noch nicht. „Es dauert, bis ein neuer Wirkstoff oder eine neue Therapie Eingang in die Leitlinien für Ärzte findet“, sagt Prof. Lang. Zudem werten viele Mediziner Bakterien noch immer als Krankheitserreger, die unter Kontrolle gehalten werden müssten. „Mit gesunden Bakterien zu therapieren, das wäre der nächste Schritt.“ Dafür brauche es zahlreiche klinische Studien, um ein Mikrobiom-basiertes Medikament zulassen zu können. Erste Empfehlungen zur Anwendung von Mikrobiom verbessernden Pflegeprodukten wurden bereits in die neuste europäische Leitlinie „Neurodermitis“ aufgenommen.
Für BELANO medical hat Prof. Lang schon vor einigen Jahren aus gesunden Bakterien den Wirkstoff „stimulans“ entwickelt, der unter anderem in der Medizinischen Hautpflege „ibiotics med“ enthalten ist. „Es handelt sich um ein Peptid, also Aminosäure-Verbindungen, die vom Milchsäurebakterium Levilactobacillus brevis gebildet werden“, erläutert Lang in dem Beitrag. „Sie regen gute Bakterien wie Staphylococcus epidermidis an, sich zu vermehren. Und je mehr davon wieder auf der Haut vertreten sind, desto besser lässt sich die Menge von Entzündungsbakterien zurückdrängen.“
Studien haben gezeigt, dass bei 80 Prozent der Teilnehmenden Beschwerden wie trockene Haut, Rötungen, Brennen, Stechen, Juckreiz und Entzündungen binnen weniger Tage abklangen. Kortison-haltige Präparate, die Nebenwirkungen haben können, konnten dadurch reduziert oder zum Teil ganz darauf verzichtet werden.
Ernährung und Diabetes haben Auswirkungen auf Hautgesundheit
Die Vielfalt von Bakterien auf der Haut (Haut-Mikrobiom) könne auch durch die Ernährung gefördert werden. Von dieser so genannten Darm-Haut-Achse wisse man bereits, „dass die Darmbakterien mit der Oberfläche der Darmschleimhaut reagieren und Moleküle aussenden, die in den Körper gelangen und auch mit der Haut in Kontakt treten und ihr Immunsystem trainieren“, erklärt Prof. Lang in dem Beitrag. „Was wir zu uns nehmen, wird im Magen und Dünndarm verdaut und über den Blutkreislauf im Körper verteilt, Vitamine etwa.“ Was der Körper nicht brauche, scheide er aus, oder schwitze es über die Haut in Form von Wasser, Zucker, Eiweißen, Fetten oder Säuren aus.
Das sei dann wiederum „Futter für die Mikroben“, heißt es in dem Beitrag. Das Absondern über die Haut bestimme wiederum, welche Bakterien sich davon besonders gut ernähren könnten. Prof. Lang: „Eine Studie hat gezeigt, dass Diabetiker, die ja einen erhöhten Blutzuckerspiegel haben, auch mehr Zucker beim Schwitzen an die Haut abgeben. Davon ernähren sich aber bevorzugt Entzündungsbakterien wie Staphylococcus aureus.“ In der Folge leide etwa jeder dritte Diabetiker auch an trockener Haut oder Juckreiz. Das Magazin verweist auf eine französische Studie, nach der ein Ungleichgewicht des Darm-Mikrobioms allergische Hautreaktionen und etwa auch Neurodermitis begünstigen könne.
Prof. Lang betont daher, dass bei der Behandlung von Hautproblemen und Hautkrankheiten immer beide – Darmflora wie Hautflora – betrachtet werden müssen. Das werde sich auch auf die Forschung und Entwicklung in Biotechnologie-Unternehmen wie BELANO medical auswirken.
Die BELANO medical AG ist ein Biotechnologie-Unternehmen, das die Ergebnisse aus der Erforschung positiv wirkender Mikroorganismen für Medizin- und Pflegeprodukte nutzt. Dabei werden neuartige Therapieansätze für medizinische Hautpflege, zur Prävention von Krankheiten und zur Unterstützung von Heilungsprozessen entwickelt und vermarktet. Auf diese Weise sollen neue Therapie-Optionen für bisher nicht befriedigend behandelbare Erkrankungen und Indikationen entstehen. Ziel ist es, diese patentgeschützten Wirkstoffe und deren Produkte für jeden Menschen verfügbar zu machen. Das Unternehmen setzt dabei auf die nationale und internationale Zusammenarbeit mit Distributoren und anderen Partnern wie die Henkel AG oder die Drogeriemarktkette Müller.
Firmenkontakt
BELANO medical AG
Johannes Lang
Neuendorfstraße 19
16761 Hennigsdorf bei Berlin
(03302) 86 37 995
info@belanomedical.com
http://www.belanomedical.com
Pressekontakt
BELANO medical AG / Claudius Kroker · Text & Medien
Prof. Dr. Christine Lang
Neuendorfstraße 19
16761 Hennigsdorf bei Berlin
(03302) 86 37 995
belano@ck-bonn.de
http://www.belanomedical.com
Die Bildrechte liegen bei dem Verfasser der Mitteilung.